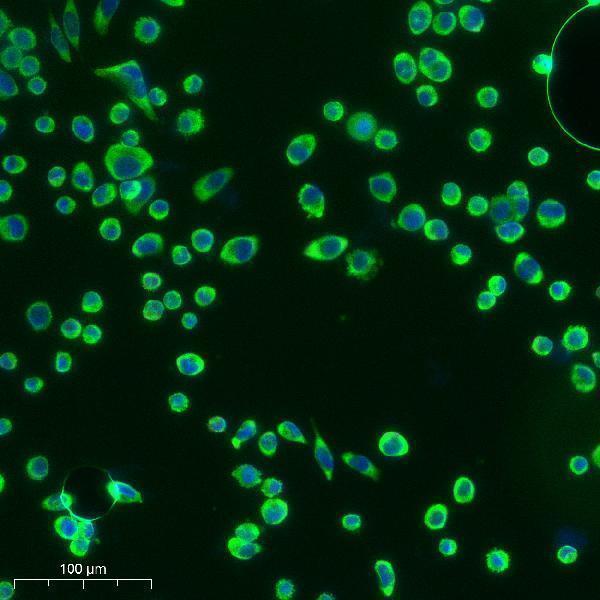
a09374 ctsv primary antibodies if testing 1

Product Info Summary
| SKU: | A09374 |
|---|---|
| Size: | 100μl |
| Reactive Species: | Human, Monkey |
| Host: | Rabbit |
| Application: | ELISA, WB |
Customers Who Bought This Also Bought
Product info
Product Name
Anti-Cleaved-Cathepsin L2 (L114) CTSV Antibody
SKU/Catalog Number
A09374
Size
100μl
Form
Liquid
Description
Boster Bio Anti-Cleaved-Cathepsin L2 (L114) CTSV Antibody catalog # A09374. Tested in WB, ELISA applications. This antibody reacts with Human, Monkey.
Storage & Handling
Store at -20°C for one year. For short term storage and frequent use, store at 4°C for up to one month. Avoid repeated freeze-thaw cycles.
Cite This Product
Anti-Cleaved-Cathepsin L2 (L114) CTSV Antibody (Boster Biological Technology, Pleasanton CA, USA, Catalog # A09374)
Host
Rabbit
Contents
Liquid in PBS containing 50% glycerol, 0.5% stabilizing protein and 0.02% sodium azide.
This antibody is supplied in a stabilized formulation.
Compatibility with conjugation reactions depends on the chemistry of the conjugation method used.
For conjugation methods that are not compatible with the stabilizing components present in this formulation, a carrier-free antibody format is required.
Clonality
Polyclonal
Isotype
IgG
Immunogen
The antiserum was produced against synthesized peptide derived from human CATL2. AA range:95-144
Cross-reactivity
No cross reactivity with other proteins.
Reactive Species
A09374 is reactive to CTSV in Human, Monkey
Observed Molecular Weight
39 kDa
Calculated molecular weight
37.3 kDa
Antibody Validation
Boster validates all antibodies on WB, IHC, ICC, Immunofluorescence, and ELISA with known positive control and negative samples to ensure specificity and high affinity, including thorough antibody incubations.
Application & Images
Applications
A09374 is guaranteed for ELISA, WB Boster Guarantee
Recommend Dilution
WB 1:500-1:2000
ELISA 1:20000
Validation Images & Assay Conditions

Click image to see more details
Western Blot analysis of various cells using Cleaved-Cathepsin L2 (L114) Polyclonal Antibody

Click image to see more details
Western blot analysis of lysates from 293 and COS cells, treated with etoposide 25uM 1h, using CATL2 (Cleaved-Leu114) Antibody. The lane on the right is blocked with the synthesized peptide.
Click image to see more details
Immunofluorescence analysis of Siha cell. 1, primary Antibody was diluted at 1:100 (4°C overnight). 2, Goat Anti Rabbit IgG (H&L) - AFluor 488 Secondary antibody was diluted at 1:500 (room temperature, 50min).
Specific Publications For Anti-Cleaved-Cathepsin L2 (L114) CTSV Antibody (A09374)
Loading publications
Recommended Resources
Here are featured tools and databases that you might find useful.
- Boster's Pathways Library
- Protein Databases
- Bioscience Research Protocol Resources
- Data Processing & Analysis Software
- Photo Editing Software
- Scientific Literature Resources
- Research Paper Management Tools
- Molecular Biology Software
- Primer Design Tools
- Bioinformatics Tools
- Phylogenetic Tree Analysis
Customer Reviews
Have you used Anti-Cleaved-Cathepsin L2 (L114) CTSV Antibody?
Share your experimental results or join a short interview to earn up to $1,000 in product credits or other rewards.
0 Reviews For Anti-Cleaved-Cathepsin L2 (L114) CTSV Antibody
Customer Q&As
Have a question?
Find answers in Q&As, reviews.
Can't find your answer?
Submit your question
7 Customer Q&As for Anti-Cleaved-Cathepsin L2 (L114) CTSV Antibody
Question
Is this A09374 anti-Cleaved-Cathepsin L2 (L114) antibody reactive to the isotypes of CTSV?
Verified Customer
Verified customer
Asked: 2020-03-17
Answer
The immunogen of A09374 anti-Cleaved-Cathepsin L2 (L114) antibody is Synthesized peptide derived from the Internal region of human Cathepsin L2. at AA rangle: 70-150. Could you tell me which isotype you are interested in so I can help see if the immunogen is part of this isotype?
Boster Scientific Support
Answered: 2020-03-17
Question
I was wanting to use your anti-Cleaved-Cathepsin L2 (L114) antibody for WB for human kidney thymus on frozen tissues, but I want to know if it has been validated for this particular application. Has this antibody been validated and is this antibody a good choice for human kidney thymus identification?
Verified Customer
Verified customer
Asked: 2020-02-05
Answer
As indicated on the product datasheet, A09374 anti-Cleaved-Cathepsin L2 (L114) antibody has been validated for WB on human, monkey tissues. We have an innovator award program that if you test this antibody and show it works in human kidney thymus in IHC-frozen, you can get your next antibody for free.
Boster Scientific Support
Answered: 2020-02-05
Question
I have a question about product A09374, anti-Cleaved-Cathepsin L2 (L114) antibody. I was wondering if it would be possible to conjugate this antibody with biotin. I would need it to be without BSA or sodium azide. I am planning on using a buffer exchange of sodium azide with PBS only. Would there be problems for me to conjugate the antibody and store it in -20 degrees in small aliquots?
Verified Customer
Verified customer
Asked: 2019-03-26
Answer
It is not recommended storing this antibody with PBS buffer only in -20 degrees. If you want to store it in -20 degrees it is best to add some cryoprotectant like glycerol. If you want carrier free A09374 anti-Cleaved-Cathepsin L2 (L114) antibody, we can provide it to you in a special formula with trehalose and/or glycerol. These molecules will not interfere with conjugation chemistry and provide a good level of protection for the antibody from degradation. Please be sure to specify this in your purchase order.
Boster Scientific Support
Answered: 2019-03-26
Question
We are currently using anti-Cleaved-Cathepsin L2 (L114) antibody A09374 for monkey tissue, and we are happy with the WB results. The species of reactivity given in the datasheet says human, monkey. Is it true that the antibody can work on pig tissues as well?
Verified Customer
Verified customer
Asked: 2018-01-04
Answer
The anti-Cleaved-Cathepsin L2 (L114) antibody (A09374) has not been tested for cross reactivity specifically with pig tissues, but there is a good chance of cross reactivity. We have an innovator award program that if you test this antibody and show it works in pig you can get your next antibody for free. Please contact me if I can help you with anything.
Boster Scientific Support
Answered: 2018-01-04
Question
Would anti-Cleaved-Cathepsin L2 (L114) antibody A09374 work for WB with kidney thymus?
E. Patel
Verified customer
Asked: 2017-10-23
Answer
According to the expression profile of kidney thymus, CTSV is highly expressed in kidney thymus. So, it is likely that anti-Cleaved-Cathepsin L2 (L114) antibody A09374 will work for WB with kidney thymus.
Boster Scientific Support
Answered: 2017-10-23
Question
I see that the anti-Cleaved-Cathepsin L2 (L114) antibody A09374 works with WB, what is the protocol used to produce the result images on the product page?
G. Patel
Verified customer
Asked: 2014-08-19
Answer
You can find protocols for WB on the "support/technical resources" section of our navigation menu. If you have any further questions, please send an email to support@bosterbio.com
Boster Scientific Support
Answered: 2014-08-19
Question
Is a blocking peptide available for product anti-Cleaved-Cathepsin L2 (L114) antibody (A09374)?
L. Roberts
Verified customer
Asked: 2014-03-20
Answer
We do provide the blocking peptide for product anti-Cleaved-Cathepsin L2 (L114) antibody (A09374). If you would like to place an order for it please contact support@bosterbio.com and make a special request.
Boster Scientific Support
Answered: 2014-03-20




